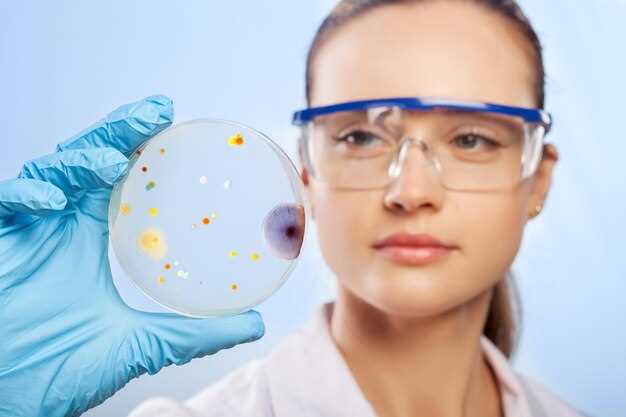

Чтобы понять механизмы памяти клеток, необходимо обратить внимание на эпигенетические изменения, которые происходят в ответ на различные внешние воздействия. Эти изменения определяют, как клетки реагируют на сигналы и адаптируются к изменениям в окружающей среде. Клеточная биология предоставляет инструменты для изучения этих процессов на молекулярном уровне.
Современные исследования показывают, что эпигеном играет ключевую роль в формировании долговременной памяти клеток. Эпигенетические модификации, такие как метилирование ДНК и модификации гистонов, влияют на экспрессию генов, участвующих в клеточной памяти. Анализ этих механизмов открывает новые горизонты для понимания процессов дифференцировки и репарации клеток.
Результаты последних экспериментов подчеркивают значимость эпигенетических маркеров в биологических реакциях и долговременной адаптации клеток. Изучение влияния различных факторов на эпигеном может стать основой для разработки новых подходов в биомедицине и терапии заболеваний, связанных с нарушениями памяти клеток.
Как эпигеном влияет на клеточную память и ее восстановление?

Эпигеном играет ключевую роль в формировании и восстановлении клеточной памяти, влияя на экспрессию генов и обеспечивая биологическую память клеток. Эпигенетические изменения, такие как метилирование ДНК и модификации гистонов, регулируют активность генов, что особенно важно в процессе развития клеток.
Исследования показывают, что эпигенетические факторы могут изменять ответ клеток на внешние воздействия, например, на стресс или повреждения. Это важно при восстановлении функций тканей и органов после травм или болезней. В результате активации определённых генов происходит восстановление клеточной памяти, позволяющее клеткам запоминать свои функции и адаптироваться к изменениям.
Новое поколение исследований в области эпигенетики предлагает способы модификации эпигенома для улучшения процессов медицинской реабилитации. Например, коррекция эпигенетических изменений может способствовать восстановлению утраченной функции клеток, особенно в нейронных и стволовых клетках.
Доказано, что молекулярная генетика и эпигенетика взаимодействуют, формируя уникальные механизмы памяти клеток. Использование специфических ингибиторов или активаторов эпигенетических изменений может привести к новым подходам в терапии различных заболеваний. Таким образом, понимание механизма влияния эпигенома на клеточную память открывает новые горизонты в области медицины и биологии.
Новые открытия в эпигенетике: как они меняют понимание биологии клеток
Исследования в области эпигенетики выявили, что эпигенетические изменения играют ключевую роль в биологической памяти клеток и их развитии. Например, новые механизмы наследования показывают, как внешние воздействия могут изменять экспрессию генов и передаваться следующему поколению клеток.
- Эпигеном формирует уникальные профили регуляции генов, что влияет на функционирование клеток в различных условиях.
- Отмечены открытия, связанные с модификациями ДНК, такими как метилирование, которые регулируют активность генов без изменения их последовательности.
- Изучение микроРНК показало, как они участвуют в передаче сигналов между клетками, управляя процессами дифференцировки и роста.
- Некоторые эпигенетические изменения оказывают долговременное воздействие на клеточную память, что открывает новые горизонты в понимании процессов старения и заболеваний.
Таким образом, новые данные позволяют лучше понять, каким образом клетки адаптируются к изменениям в окружающей среде, и открывают перспективы для разработки терапий, направленных на восстановление нормальной регуляции генов. Эпигенетика предоставляет инструменты для манипулирования клеточной памятью, что может изменить подходы к лечению различных заболеваний.
Практическое значение эпигеномных исследований в медицине и терапии заболеваний

Эпигеномные исследования открывают новые горизонты в терапии различных заболеваний, исследуя, как эпигенетические факторы влияют на функции клеток и их память. Изучение механизмов наследования позволяет определить, как изменения в эпигеноме клеток способствуют развитию патологии. Например, модификации ДНК и гистонов могут существенно влиять на экспрессию генов, что важно для понимания раковых заболеваний.
Анализ клеточной памяти через эпигеном помогает выявить биомаркеры для диагностики и прогноза. Методики, основанные на эпигенетическом профилировании, уже используются для разработки персонализированной терапии, учитывающей индивидуальные особенности пациента. Это позволяет более точно прогнозировать ответ организма на лечение.
Исследования показывают, что эпигеном может быть подвержен влиянию внешних факторов, таких как диета и стресс, что делает его потенциальной мишенью для вмешательства. Понимание этих взаимодействий открывает двери для создания новых терапевтических стратегий, направленных на восстановление нормального эпигенетического баланса в клетках.
Дополнительно, эпигеномные изменения могут служить генетическими маркерами для наследственных заболеваний. Применение технологий редактирования эпигенома, таких как CRISPR, позволяет осуществлять точное воздействие на дисфункции, связанные с определёнными заболеваниями, что кардинально меняет подход к терапии.
Таким образом, интеграция эпигеномных исследований в молекулярную генетику требует постоянного внимания, поскольку это может привести к успехам в разработке инновационных подходов к лечению и профилактике заболеваний.








